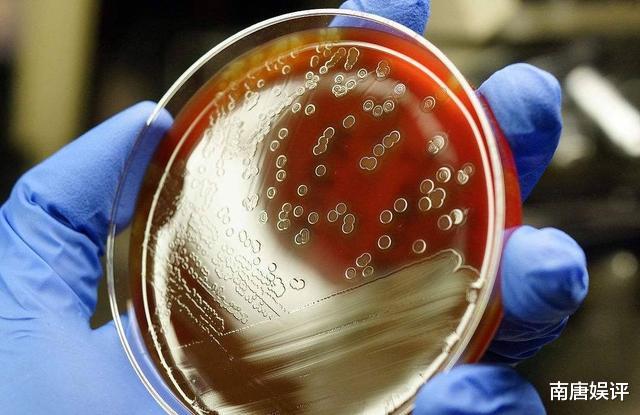
华为|打压华为？中国手中还有张王牌没出，白宫前顾问：能摧毁美国

еҚҺдёә|жү“еҺӢеҚҺдёәпјҹдёӯеӣҪжүӢдёӯиҝҳжңүеј зҺӢзүҢжІЎеҮәпјҢзҷҪе®«еүҚйЎҫй—®пјҡиғҪ摧жҜҒзҫҺеӣҪ

ж–Үз« еӣҫзүҮ
ж–Үз« еӣҫзүҮ
гҖҗеҚҺдёә|жү“еҺӢеҚҺдёәпјҹдёӯеӣҪжүӢдёӯиҝҳжңүеј зҺӢзүҢжІЎеҮәпјҢзҷҪе®«еүҚйЎҫй—®пјҡиғҪ摧жҜҒзҫҺеӣҪгҖ‘
ж–Үз« еӣҫзүҮ

ж–Үз« еӣҫзүҮ
зҫҺеӣҪж”ҝеәңеңЁй’ҲеҜ№еҚҺдёәзҡ„ жү“еҺӢж”ҝзӯ–дёҠ пјҢ ж„Ҳжј”ж„Ҳ зғҲ пјҢ еҲ¶иЈҒзҡ„зӯ–з•ҘжӣҙжҳҜдёҚж–ӯеҚҮзә§ гҖӮ еҰӮд»ҠеҚҺдёәзҡ„ж—ҘеӯҗиҷҪ然дёҚз®—еҘҪиҝҮ пјҢ дҪҶжҳҜжңү专家表зӨә пјҢ еҰӮжһңзҫҺеӣҪд»ҚдёҖж„ҸеӯӨиЎҢжү“еҺӢеҚҺдёәпјҹйӮЈд№ҲиҰҒжіЁж„ҸдәҶ пјҢ дёӯеӣҪжүӢдёӯиҝҳжңүеј зҺӢзүҢжІЎеҮә гҖӮ 继з»ӯеҜ№еҚҺдёәе®һж–Ҫжү“еҺӢ пјҢ йӮЈд№ҲдёӯеӣҪд№ҹдјҡеҜ№зҫҺеӣҪйҮҮеҸ–дёҖдәӣйҷҗеҲ¶жүӢж®ө пјҢ з»ҙжҠӨиҮӘе·ұзҡ„еҗҲжі•еҲ©зӣҠ гҖӮ
иҝҷеј зҺӢзүҢд»Җд№ҲпјҹжҲ‘们йғҪзҹҘйҒ“ зҫҺеӣҪжһҒеәҰдҫқиө–д»ҺдёӯеӣҪиҝӣеҸЈеҺҹж–ҷиҚҜзү© пјҢ е°Өе…¶жҳҜжҠ—з”ҹзҙ дёҖзұ» пјҢ еҮ д№ҺйғҪжҳҜз”ұдёӯеӣҪиҝӣиЎҢз”ҹдә§е’Ңдҫӣеә”зҡ„ гҖӮ дёҖдәӣеҫҲеёёз”Ёзҡ„иҚҜд№ҹжҳҜжқҘжәҗдәҺдёӯеӣҪ пјҢ жңү专家称 дёӯеӣҪйҷҗеҲ¶еҜ№зҫҺеӣҪеҮәеҸЈиҝҷдәӣеҺҹж–ҷиҚҜзү© пјҢ жҲ–иҖ…жҳҜи°ғй«ҳиҚҜд»· пјҢ йӮЈд№ҲзҫҺеӣҪ еҜ№дәҺзҫҺеӣҪзҡ„еҪұе“Қе°ҶжҳҜеҫҲеӨ§зҡ„ гҖӮ еӣ дёәзҫҺеӣҪзҺ°йҳ¶ж®өжҳҜжІЎжңүеҠһжі•еҺ»еӨ§йҮҸиҝӣиЎҢз”ҹдә§зҡ„ пјҢ зҫҺеӣҪзҺ°еңЁеҜ№ж–°еҶ з–«жғ…е·Із»ҸеӨ„дәҺж”ҫжүӢдёҚз®Ўзҡ„жҖҒеәҰ пјҢ еҸҜд»ҘиҜҙжҳҜ еҲҶиә«д№ҸжңҜдәҶ гҖӮ зҫҺеӣҪиӢҘ继з»ӯжү“еҺӢеҚҺдёә пјҢ 专家称еҸҜзӣҙжҺҘйҷҗеҲ¶иҚҜзү©еҮәеҸЈ пјҢ е°ұиғҪеҸҚеҲ¶зҫҺеӣҪ гҖӮ
зҫҺеӣҪдҫқиө–зҡ„жүҖжңүдёӯеӣҪиҚҜйғҪеҸҜд»ҘеҪұе“ҚеҲ°жң¬еӣҪзҡ„иҚҜе“Ғз”ҹдә§ пјҢ е°ұжӢҝжӯўз—ӣиҚҜи·ҹжҠ—з”ҹзҙ жқҘиҜҙ пјҢ еҚідҫҝжҳҜжҲ‘们и§үеҫ—еҫҲе№іеёёзҡ„йҳҝеҸёеҢ№жһ— пјҢ еңЁзҫҺеӣҪзҡ„жүҖжңүиҚҜе“ҒйҮҢйқў пјҢ йғҪиғҪжүҫеҲ°дёӯеӣҪзҡ„еҺҹж–ҷж”ҜжҢҒ пјҢ еҸҜд»ҘиҜҙдёҖдәӣеёёз”Ёзҡ„иҚҜе“Ғ пјҢ зҫҺеӣҪж №жң¬дёҚиҮӘе·ұиҝӣиЎҢз”ҹдә§ гҖӮ
еҚідҫҝжҳҜзҫҺеӣҪеҜ№дәҺдёӯеӣҪиҚҜе“Ғдҫқиө–еҰӮжӯӨе·ЁеӨ§ пјҢ дҪҶжҳҜзү№жң—жҷ®еҚҙдёҚд»Ҙдёә然 пјҢ зү№жң—жҷ®е§Ӣз»Ҳи®Өдёә пјҢ еҸҜд»ҘдёҚд»ҺдёӯеӣҪеҺ»иҝӣеҸЈиҚҜе“ҒеҺҹж–ҷ пјҢ еҸҰеӨ–жүҫе…¶д»–зҡ„еӣҪ家иҝӣиЎҢиҙӯд№° гҖӮ 然иҖҢдәӢе®һдёҠ пјҢ ж—©еңЁ20е№ҙеүҚ пјҢ дёӯеӣҪзҡ„йқ’йңүзҙ з”ҹдә§жҖ»йҮҸе°ұе·Із»ҸиҫҫеҲ°дәҶдё–з•Ң60%зҡ„еёӮеңәд»Ҫйўқ гҖӮ дёҖзӣҙеҲ°д»ҠеӨ© пјҢ дёӯеӣҪзҡ„жҠ—з”ҹзҙ и·ҹиҘҝиҚҜзҡ„дә§е“Ғе·Із»Ҹиҝңй”Җдё–з•ҢдёҠеҮ зҷҫдёӘеӣҪ家 пјҢ е…¶дёӯеҢ…жӢ¬дёҚе°‘еҸ‘иҫҫеӣҪ家 пјҢ е°Өе…¶жҳҜд»Ҙ зҫҺеӣҪеұ…йҰ– пјҢ еҸҜд»ҘиҜҙ зҫҺеӣҪзҡ„иҚҜе“ҒеҺҹж–ҷ80%йғҪжҳҜдёӯеӣҪзҡ„дҫӣеә” гҖӮ
зҫҺеӣҪзҷҪе®«зҡ„еүҚйЎҫ问科жҒ©еҜ№зү№жң—жҷ®зҡ„дёҫеҠЁиЎЁзӨәжӢ…еҝ§ пјҢ д»–иЎЁзӨәеҰӮжһңдёӯеӣҪжүӢдёӯеҮәиҝҷеј зҺӢзүҢ пјҢ йӮЈд№ҲиғҪ摧жҜҒзҫҺеӣҪ гҖӮ иҷҪ然 зҫҺеӣҪеҸҜд»Ҙд»Һе…¶д»–еӣҪ家еҺ»иҝӣеҸЈиҚҜе“ҒеҺҹж–ҷ пјҢ дҪҶе®һйҷ…дёҠ пјҢ зӣ®еүҚеҸӘжңүдёӯеӣҪе…·еӨҮжңүеӨ§йҮҸеҮәеҸЈжҠ—з”ҹзҙ иҚҜзү©зҡ„иғҪеҠӣ пјҢ еҗҢж—¶дёӯеӣҪд№ҹжҳҜжһҒе°‘ж•°иғҪеӨҹеӨ§жү№йҮҸз”ҹдә§жҠ—з”ҹзҙ зҡ„еӣҪ家 гҖӮ йҷӨдәҶзҫҺеӣҪд»ҘеӨ– пјҢ еҫ·еӣҪжҜҸе№ҙд№ҹд»ҺдёӯеӣҪиҝӣеҸЈеӨ§йҮҸзҡ„иҚҜе“ҒеҺҹж–ҷ пјҢ жӢҝжҠ—з”ҹзҙ дёәдҫӢ пјҢ еҚідҫҝжҳҜзҫҺеӣҪеҸҜд»Ҙд»Һеҫ·еӣҪиҝӣеҸЈ пјҢ дҪҶжҳҜеҫ·еӣҪеҠҝеҝ…дјҡеҠ е·®д»· пјҢ 然еҗҺеҶҚеҮәеҸЈеҲ°зҫҺеӣҪ пјҢ иҝҷ е®һйҷ…дёҠиҝҳжҳҜжІЎжңүи„ұзҰ»еҜ№дёӯеӣҪеҺҹж–ҷзҡ„дҫқиө– пјҢ еҸӘжҳҜеўһеҠ дәҶдёҖдёӘдёӯй—ҙе•Ҷзҡ„жё йҒ“иҖҢе·І пјҢ еҜ№зҫҺеӣҪиҖҢиЁҖ пјҢ з»ҸжөҺд»Қ然жҳҜиө·дёҚеҲ°д»»дҪ•еўһй•ҝе’ҢеҠ©еҠӣ гҖӮ
дёҖдәӣ专家иӯҰе‘Ҡз§° пјҢ еҰӮжһңзҫҺеӣҪ继з»ӯдёҖж„ҸеӯӨиЎҢ пјҢ дёӯеӣҪдјҡеҒңжӯўеҜ№зҫҺеӣҪдҫӣеә”е…ій”®зҡ„жҠ—з”ҹзҙ д»ҘеҸҠе…¶д»–иҚҜзү© пјҢ дёҚжҺ’йҷӨеҪ»еә•йҳ»ж–ӯеҜ№зҫҺеӣҪиҚҜе“ҒеҺҹж–ҷзҡ„дҫӣеә” гҖӮ
йҷӨдәҶиҝҷеј зҺӢзүҢ пјҢ зҫҺеӣҪе…¶д»–ж–№йқўдҫқ然жңүиө–дәҺдёӯеӣҪжҸҗдҫӣж”ҜжҢҒе’Ңеё®еҠ© пјҢ еҰӮзЁҖеңҹ пјҢ зҫҺеӣҪи®ёеӨҡеҶӣе·ҘдјҒдёҡйғҪжңүйңҖжұӮд»ҺдёӯеӣҪиҝӣеҸЈ пјҢ и®ёеӨҡзҡ„з§‘з ”жӯҰеҷЁйғҪиҰҒдҫқиө–зЁҖеңҹиҝӣиЎҢз ”з©¶ гҖӮ еҰӮжһңдёӯеӣҪеҒңжӯўеҜ№зҫҺеӣҪзЁҖеңҹзҡ„жҸҗдҫӣ пјҢ йӮЈд№ҲзҫҺеӣҪзҡ„еҶӣе·Ҙдә§дёҡй“ҫе°Ҷж— жі•з”ҹдә§е’Ңз ”еҸ‘ пјҢ зЁҖеңҹзҡ„жҸҗзәҜжҠҖжңҜ пјҢ зӣ®еүҚеҸӘжңүдёӯеӣҪжҺҢжҸЎиҝҗз”Ё гҖӮ
еҸҰеӨ–дёӯеӣҪиҝҳжҳҜ зҫҺеӣҪеӨ§иұҶзӯүеҶңдҪңзү©зҡ„иҝӣеҸЈеӣҪ пјҢ жҜҸе№ҙдёәзҫҺеӣҪеёҰжқҘзҡ„иҙёжҳ“收е…ҘжӣҙжҳҜдёҖ笔дёҚиҸІзҡ„收зӣҠ пјҢ еҰӮжһңеҪўеҠҝ继з»ӯжҒ¶еҢ– пјҢ дёӯеӣҪдјҡиҖғиҷ‘жүҫе…¶д»–еӣҪ家жӣҝд»ЈзҫҺеӣҪ пјҢ еұҠж—¶зҫҺеӣҪзҡ„еӨ§иұҶеҸҠеҶңдҪңзү©дә§е“Ғд№ҹдјҡеӨұеҺ»дёӯеӣҪзҡ„еӨ§з¬”и®ўеҚ• гҖӮ
жҺЁиҚҗйҳ…иҜ»
- иҲӘеӨ©еҷЁ|дёӯеӣҪеҸҜйҮҚеӨҚдҪҝз”ЁиҲӘеӨ©еҷЁеҲҡеҸ‘е°„жҲҗеҠҹпјҢзҫҺеӘ’е°ұжқҘд№ұеј№зҗҙпјҡжҲ–жҳҜеӨӘз©әжӯҰеҷЁ
- дёӯеӣҪиҠҜ|йҰ–ж¬ҫ100%вҖңдёӯеӣҪиҠҜвҖқеҮәзӮүпјҢиҝҷжүҚжҳҜзңҹжӯЈзҡ„еӨ§дҪң
- еҚҺдёә|йә’йәҹ9000еә“еӯҳеҸҜжңҹпјҢдҪҷжүҝдёңж”ҫеҮәзҢӣж–ҷпјҢеҸ°з§Ҝз”өд»ҚеңЁдёәеҚҺдёәд»Је·Ҙ
- еҚҺдёә|еҚҺдёәеҶҚж·»дёҖеӨ§еҲ©еҷЁпјҢй«ҳз«Ҝе…үеҲ»жңәеҮ д№ҺжІЎз”ЁдәҶпјҢжҜҸе№ҙеҸҜиҠӮзңҒж•°дёҮдәҝиө„йҮ‘
- еҚҺдёә|е…үеҲ»жңәе°ҶжҲҗеәҹй“ҒпјҹеҚҺдёәвҖңйҮҚзЈ…вҖқеҮәзҺ°пјҢзҪ‘еҸӢж„ҹж…ЁпјҡеҺүе®ідәҶпјҢеҚҺдёә
- еҚҺдёәиҚЈиҖҖ|иҚЈиҖҖ30 proи·ҢиҮівҖңеӯҰз”ҹд»·вҖқпјҢе°Ҹзұі10йҰ–еҪ“е…¶еҶІпјҒ
- еҚҺдёәmate|еҚҺдёәmate40еҚіе°ҶеҸ‘еёғпјҒеҸҢжӣІйқў+90Hz+йә’йәҹиҠҜпјҢиғҪд№°еҲ°е…Ёйқ иҝҗж°”
- ж°ҙеә•еҘҘз§ҳ|е…ЁзҗғжңҖеӨ§ж·Ўж°ҙйұјпјҢдҪ“й•ҝеҸҜиҫҫ2зұіпјҢжқҘеҲ°дёӯеӣҪеҚҙеҮәзҺ°вҖңз”ҹеӯҳеҚұжңәвҖқ
- йҳҝйҮҢе·ҙе·ҙ|еҚҺдёәе’ҢйҳҝйҮҢе·ҙе·ҙи°Ғзҡ„еӣҪйҷ…еҪұе“Қд№ҹжӣҙеӨ§пјҢ马дә‘пјҡдҪ и§ҒиҝҮзү№жң—жҷ®еҗ—пјҹ
- еҚҺдёә|еҚҺдёә专家жӢҝдёҠзҷҫдёҮе№ҙи–ӘпјҒеҚҙжҜ«ж— дҪңдёәеј•еҸ‘иҙЁз–‘пјҹд»»жӯЈйқһжһҒеҠӣиў’жҠӨпјҒ



















